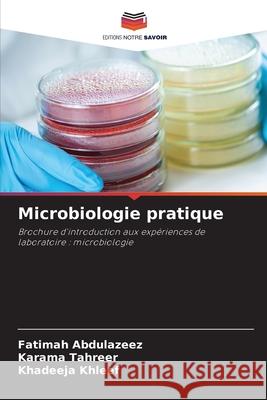
Microbiologie pratique Abdulazeez, Fatimah, Tahreer, Karama, Khleef, Khadeeja 9786208767532 Editions Notre Savoir - książka

Microbiologie pratique » książka
Microbiologie pratique
ISBN-13: 9786208767532 / Francuski / Miękka / 2025 / 60 str.
Ce livre est un manuel de laboratoire axé sur les expériences de microbiologie, plus particulièrement liées à l'identification et à la caractérisation des espèces de Mycobacterium, y compris M. tuberculosis. Il comprend divers tests tels que le test au rouge neutre, l'activité catalase, la sensibilité à la pyrazinamide, le test à l'amidase et le test de réduction des nitrates, détaillant les propriétés biochimiques de ces bactéries. En outre, il aborde les méthodes de filtration des bactéries, l'utilisation de désinfectants tels que l'éthanol et l'isopropanol, ainsi que les radiations pour la stérilisation. Dans l'ensemble, cet ouvrage constitue un guide pratique pour les étudiants et les chercheurs en microbiologie.